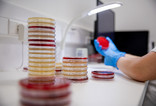
NL BioLAB Praha

Proč pracovat v Next Clinics?
Jsme skupina společností, které působí v oblasti zdravotní péče. Našimi ambicemi je posilovat inovativní postupy ve zdravotnictví a kombinovat nejmodernější metody vyšetření a léčby s osobním přístupem zdravotnického personálu k pacientům.
V České republice máme 6 společností s dlouholetou tradicí, ve kterých pracuje 350 odborníků ve svém oboru a ročně se postaráme o 35 000 pacientů a provedeme 2 000 000 laboratorních vyšetření.

Součástí mezinárodní skupiny
Jsme součástí evropské mezinárodní skupiny, která se specializuje v oblasti reprodukční medicíny.
V České republice máme navíc i síť laboratoří a ambulancí.

Široké spektrum pozic
Zaměstnanci se u nás mohou pracovně realizovat díky širokému spektru pozic a možnosti kariérního růstu v rámci skupiny.

Pomáháme lidem
Věnujeme se odvětví, které je životním posláním. Vaše zdraví má nevyčíslitelnou hodnotu, a proto mu věnujeme tolik pozornosti a snažíme se jej chránit.

Komplexní péče o klienta
V rámci skupiny Next Clinics jsme schopni poskytnout klientovi komplexní péči napříč klinikami.
Dokážeme na sebe navázat jednotlivá vyšetření a procedury a sladit termíny u odborníků.
Prezentační video skupiny Next Clinics
Benefity
Péče o naše zaměstnance je jednou z klíčových strategií skupiny Next Clinics. Chceme, aby Vás práce u nás bavila i naplňovala. Proto svým zaměstnancům nabízíme řadu zajímavých benefitů.

Podporujeme vzdělávání
Ceníme si našich zaměstnanců, kteří mají chuť se dále vzdělávat a proto je s radostí podporujeme. Uvědomujeme si, jak je obzvláště v našem oboru vzdělání důležité a je pro nás naprosto klíčové mít v našich řadách špičkové odborníky.

Moderní technologie a prvotřídní vybavení
Investujeme do špičkového vybavení a moderních technologií. Je pro nás zcela zásadní, abyste se u nás neustále rozvíjeli a získané poznatky uváděli do praxe.

Práce a osobní život
Bez rovnováhy mezi pracovním a osobním životem to nejde. Proto můžete čerpat příspěvky na wellness, kulturu a gastronomii. Využít můžete i Multisport kartu nebo nadstandardní zdravotní péči.

Něco navíc
Dáme vám týden dovolené navíc a sickdays, abyste si mohli dostatečně odpočinout. Přispíváme na penzijní nebo životní připojištění a abychom podpořili vaše zdraví, můžete absolvovat očkování proti chřipce.

Hledáme nové kolegy!
Vyberte si pracovní pozici dle svého zaměření.
|
Podporujeme další vzdělávání |
Moderní technologie a prvotřídní vybavení |
Práce a osobní život |
Nejnovější pozice
Jak to u nás vypadá?
Chcete se dozvědět více o našich klinikách, ambulancích a laboratořích?
Podívejte se na fotogalerii jednotlivých provozoven. U nás je radost pracovat!
Centrum reprodukční medicíny
Do skupiny Next Clinics patří špičková klinika reprodukční medicíny pod názvem Next Fertility IVF Prof. Zech Pilsen. Naše IVF klinika má dlouholetou tradici a nabízí komplexní péči v oblasti léčby neplodnosti.

Naše laboratoře a ambulance
Naše laboratoře poskytují rychlou a přesnou laboratorní diagnostiku pro soukromé praktické lékaře, ambulantní specialisty, nemocnice a pacienty samoplátce, kteří požadují nadstandardní laboratorní služby. Součástí některých laboratoří jsou i gynekologické ambulance.

Centrála skupiny Next Clinics
Do skupiny zdravotnických zařízení patří i administrativní centrála, která jednotlivým pracovištím zajišťuje plnou podporu s běžným fungováním provozu. Kolegové se tak mohou věnovat odborné práci.

Spřátelené ambulance
Moderní zdravotnická zařízení nabízející špičkovou ambulantní zdravotní péči. Více než 12 odborností, spolupráce s kvalitními lékaři a individuální přístup k pacientům, jsou zárukou specializovaných vyšetření, kvalitní diagnostiky a následné odborné lékařské péče.

Seznamte se s námi
Ať už nastoupíte do jakékoliv společnosti skupiny Next Clinics, vždy se můžete těšit na skvělý tým. Níže bychom Vám rádi představili vedoucí zaměstnance jednotlivých provozů.

MUDr. Ing. Kateřina Kotrčová, Ph.D.
Ředitelka IVF klinik a laboratoří

Mgr. Lucie Panýrová
Manažerka Next Lab CGOP Praha

MUDr. Petr Lošan
Zakladatel a vedoucí lékař Next Lab Genetika Plzeň

Doc. MUDr. František Lošan, CSc.
Zakladatel kliniky Next Lab Genetika Plzeň

MUDr. Natálie Mészárosová
Vedoucí laboratoře Next Lab Praha

MUDr. František Musil
Vedoucí laboratoře Next Lab Klatovy